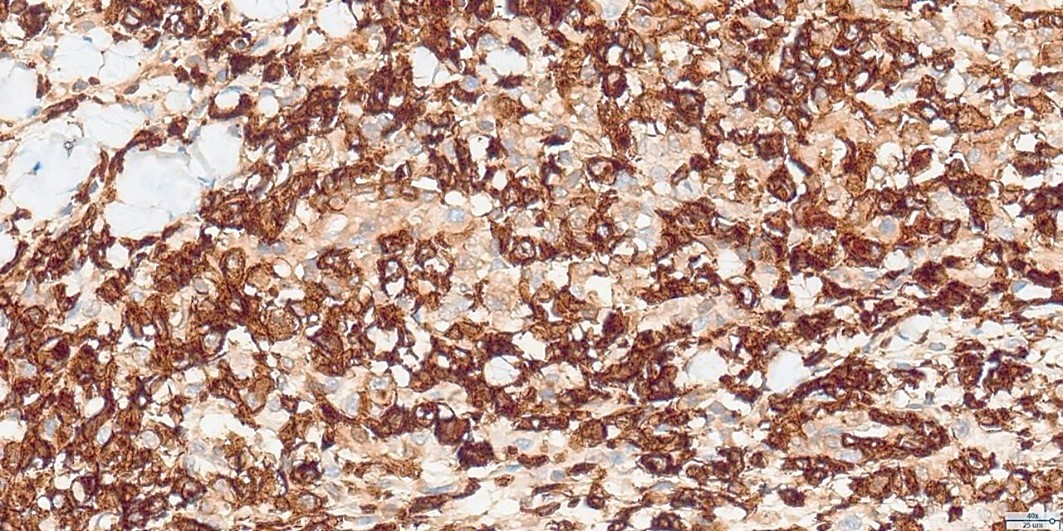
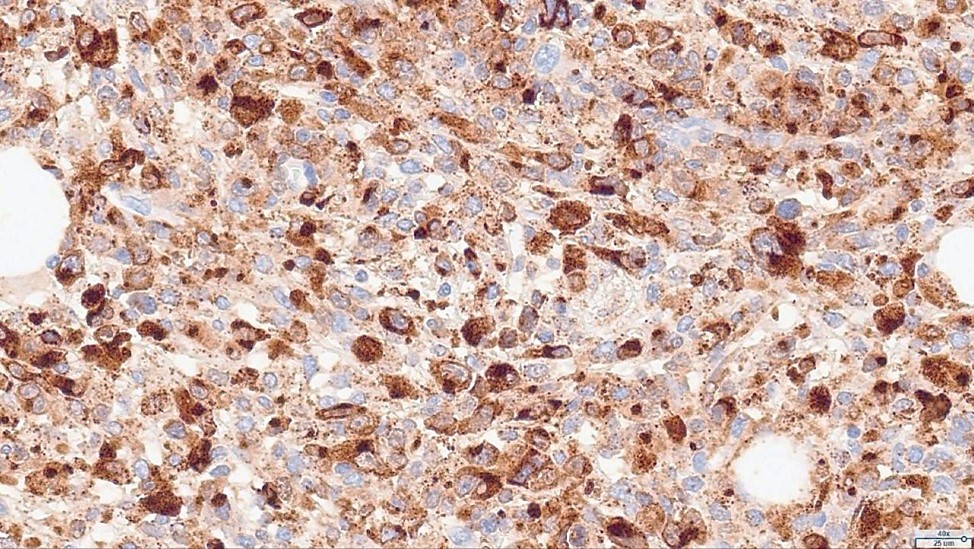

Department of Dermatology, Santa Casa de Misericórdia de Porto Alegre Hospital, Brazil
Received Date: 05/06/2025; Published Date: 08/07/2025
*Corresponding author: Bianca Fantin de Souza, Department of Dermatology, Santa Casa de Misericórdia de Porto Alegre Hospital, Rua Professor Annes Dias, 295, Centro Histórico, Porto Alegre, RS, 90020-090, Brazil
Primary cutaneous anaplastic large cell lymphoma (PCALCL) is a rare CD30-positive lymphoproliferative disorder classified as a non-Hodgkin lymphoma. We report a challenging case of a 10-year-old male presenting with an asymptomatic erythematous-violaceous nodule on the right thorax. Histopathological and immunohistochemical analyses confirmed PCALCL. The patient underwent localized electron beam radiotherapy with favorable outcomes. This case underscores the diagnostic complexity of CD30-positive cutaneous lymphomas and highlights the importance of thorough clinical and pathological evaluation.
Keywords: Primary cutaneous anaplastic large cell lymphoma; CD30-positive lymphoma; Pediatric dermatology; Immunohistochemistry; Case report
Primary cutaneous anaplastic large cell lymphoma (PCALCL) is a rare entity among CD30-positive lymphoproliferative disorders, accounting for about 1.7% of non-Hodgkin lymphomas. Clinical presentation is variable—solitary or multiple nodules, papules, plaques, or ulcerations—mostly on the trunk, extremities, and buttocks. Although more common in older males, pediatric cases are exceptional. Histopathology and immunohistochemistry are critical for diagnosis, while staging and therapeutic strategy rely on laboratory and imaging evaluation.
A 10-year-old boy, previously healthy, presented with a 14-day history of a right thoracic nodule, initially diagnosed as an abscess. He was treated with oral cefadroxil and topical fusidic acid. On examination, a well-demarcated, asymptomatic, erythematous-violaceous nodule was observed (Figure 1). Excisional biopsy was performed. The surgical defect during the procedure is shown in Figure 2.
Histopathological examination revealed a non-circumscribed proliferation of large cells with marked nuclear pleomorphism, prominent nucleoli, and abundant clear cytoplasm, with numerous mitotic figures (Figure 3). Immunohistochemistry showed strong and diffuse expression of CD30 in atypical cells (Figure 4), and positivity for granzyme B, CD2, CD4, and CD25 in atypical T-cells (Figure 5). Numerous intermingled histiocytes were positive for CD68 and CD163, but negative in the atypical cells (Figures 6 and 7). ALK1 was negative in lymphoid cells (Figure 8). These findings supported the diagnosis of primary cutaneous anaplastic large cell lymphoma. Laboratory and PET-CT evaluation showed no extracutaneous disease. Localized electron beam radiotherapy was performed.

Figure 1: Well-demarcated, asymptomatic, erythematous-violaceous nodule on the right thorax.

Figure 2: Surgical defect observed intraoperatively after excisional biopsy.

Figure 3: HE staining (40x): Proliferation of large cells with marked nuclear pleomorphism and mitotic figures.
Figure 4: Immunohistochemistry for CD30 (40x): Strong and diffuse CD30 expression in atypical cells.
Figure 5: Immunohistochemistry: Granzyme B, CD2, CD4, and CD25—positive T-cell markers in atypical cells.

Figure 6: Immunohistochemistry for CD68 (40x): Positive in numerous intermingled histiocytes, negative in atypical cells.

Figure 7: Immunohistochemistry for CD163 (10x): Positive in histiocytes, negative in atypical cells.

Figure 8: Immunohistochemistry for ALK1 (40x): Negative in atypical lymphoid cells.
The diagnosis of cutaneous lymphomas is challenging, frequently requiring extensive investigation. In PCALCL, histopathology reveals large anaplastic T-cells with prominent nuclei, eosinophilic nucleoli, and abundant cytoplasm. Immunohistochemistry typically demonstrates CD30 and CD4 positivity. EMA and TIA-1 may be positive or negative; CD15 and ALK1 are usually negative.
Differentiating PCALCL from lymphomatoid papulosis (LyP) relies on clinical, pathological, and immunohistochemical features and longitudinal observation. Spontaneous regression and smaller lesion size are more typical of LyP. PCALCL has a 5-year survival rate of 76-96%, with cutaneous recurrences in up to 39% and extracutaneous dissemination in 13%. For skin-limited disease, local radiotherapy or surgical excision are preferred. No evidence supports combined therapy over either alone.
This case highlights the diagnostic complexity of CD30-positive cutaneous lymphomas and underscores the importance of clinical, pathological, and immunohistochemical correlation. Individualized treatment and close follow-up are crucial.
Consent: Written informed consent was obtained from the patient’s legal guardian for publication of this case report and accompanying images.
Conflicts of Interest: The authors declare no conflicts of interest.
Funding: The authors received no specific funding for this work.
Acknowledgments: The authors thank the Department of Dermatology and Pathology, Santa Casa de Misericórdia de Porto Alegre Hospital, for support with the clinical case and histopathological analysis.
Author Contributions: All authors contributed to the clinical management, histopathological analysis, and preparation of the manuscript. All authors approved the final version.
